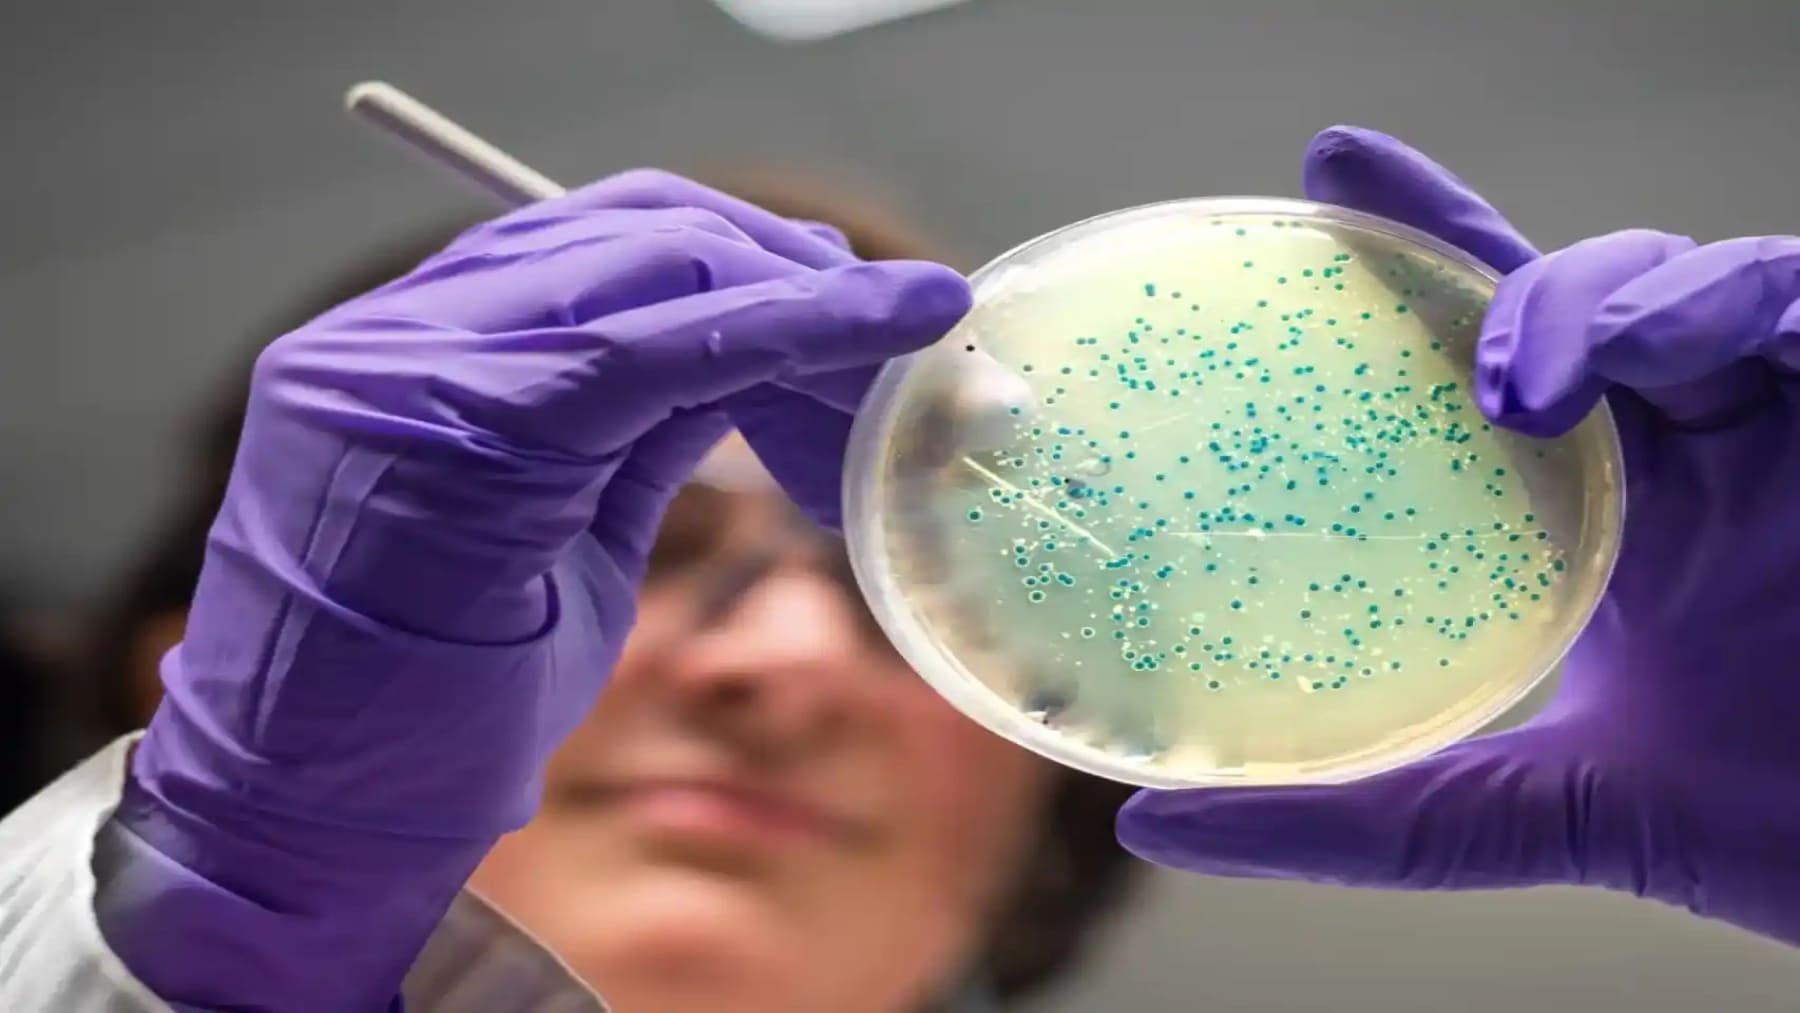
Reino Unido bacterias

Desde hace algunas décadas, el mundo ha recurrido a elementos del pasado buscando solución a problemas propios de la modernidad, los cuales han sido muy efectivos. Como ejemplo tenemos estos microbios que han sido resucitados por el Reino Unido desde la prehistoria con el fin de comenzar con algunos ataques que son selectivos para no ocasionar daños colaterales. Pasemos a ver de qué se trata.
Las baterías gastadas: una fuente de contaminación ambiental
Estos dispositivos se han convertido en parte fundamental de la industria y de la vida cotidiana, pero el caso de una vez finalizada su vida útil, si no son desechadas o gestionadas adecuadamente, se transforman en un problema ambiental ya que son muy contaminantes por los materiales que contienen, entre ellos están principalmente el litio, níquel y cobalto junto con el electrolito, los cuales son tóxicos.
Además de que no son biodegradables en el corto plazo. Una de las soluciones planteadas es incinerarlas pero los gases que se producen son muy contaminantes y es una acción que no es reversible. La mejor solución para disponer de ellas es utilizando métodos de reciclaje, como los creados por el Reino Unido, que permitan la recuperación de los metales que las componen para ser reutilizados en la industria.
El Reino Unido hace ataques que son selectivos
Una empresa del Reino Unido llamada Cell Cycle, que se especializa en reciclar baterías de diferentes tecnologías desde su fundación en 2020, ha creado un método innovador que consiste en la soltar millones de microbios de la época prehistórica sobre baterías desechadas comenzando así con muchos de ataques selectivos a estos materiales que son altamente contaminantes y son desechados inadecuadamente.
Estos ataques se hacen en número de miles, por lo que involucra una gran cantidad de bacterias (lo que se puede combinar con esta “siembra” que permite cosechar combustible). Con la ayuda de estas bacterias es posible la recuperación de elementos que son muy escasos en la naturaleza como son el cobalto, níquel y el litio. Este método es sostenible, ecológico y no genera gases perjudiciales a la atmósfera.
Y es que, con el auge de los coches eléctricos y dispositivos electrónicos, las baterías desechadas han aumentado en gran número y las técnicas actuales de disposición y tratado de las mismas requieren elementos químicos muy tóxicos, altas temperaturas y generan desechos muy perjudiciales para el medio ambiente además de la energía que consumen, por lo que Cell Cycle hace una propuesta muy interesante.
Planteada para ser usada en el Reino Unido. Consiste en utilizar microbios que desde hace más de 50 millones de años han tallado los minerales de la corteza terrestre, desplegados sobre estas baterías, para extraer estos valiosos metales. Estas bacterias son capaces de disolver sólidos, permitiendo la recuperación de elementos específicos, en un entorno a temperatura y presión ambiente, sin el uso de químicos peligrosos.
Los beneficios de esta forma de reciclar
Las principales ventajas de esta técnica de reciclaje de baterías aplicada en el Reino Unido son del tipo ambiental y económico. Puesto que, como el sistema es hermético, no se producen desechos tóxicos al entorno, por otra parte, las bacterias emiten oxígeno del proceso del CO2 por lo que se considera que el método es de emisión negativa, así que su huella es mínima en carbono.
Concluyendo, en el Reino Unido se ha implementado un método muy innovador para el reciclaje de baterías (lo que debería hacer que España rectifique y así corrija su fracaso histórico en el tema). Este consiste en la liberación de bacterias prehistóricas encima de las baterías desechadas, como serían ataques selectivos contra estos elementos contaminantes.